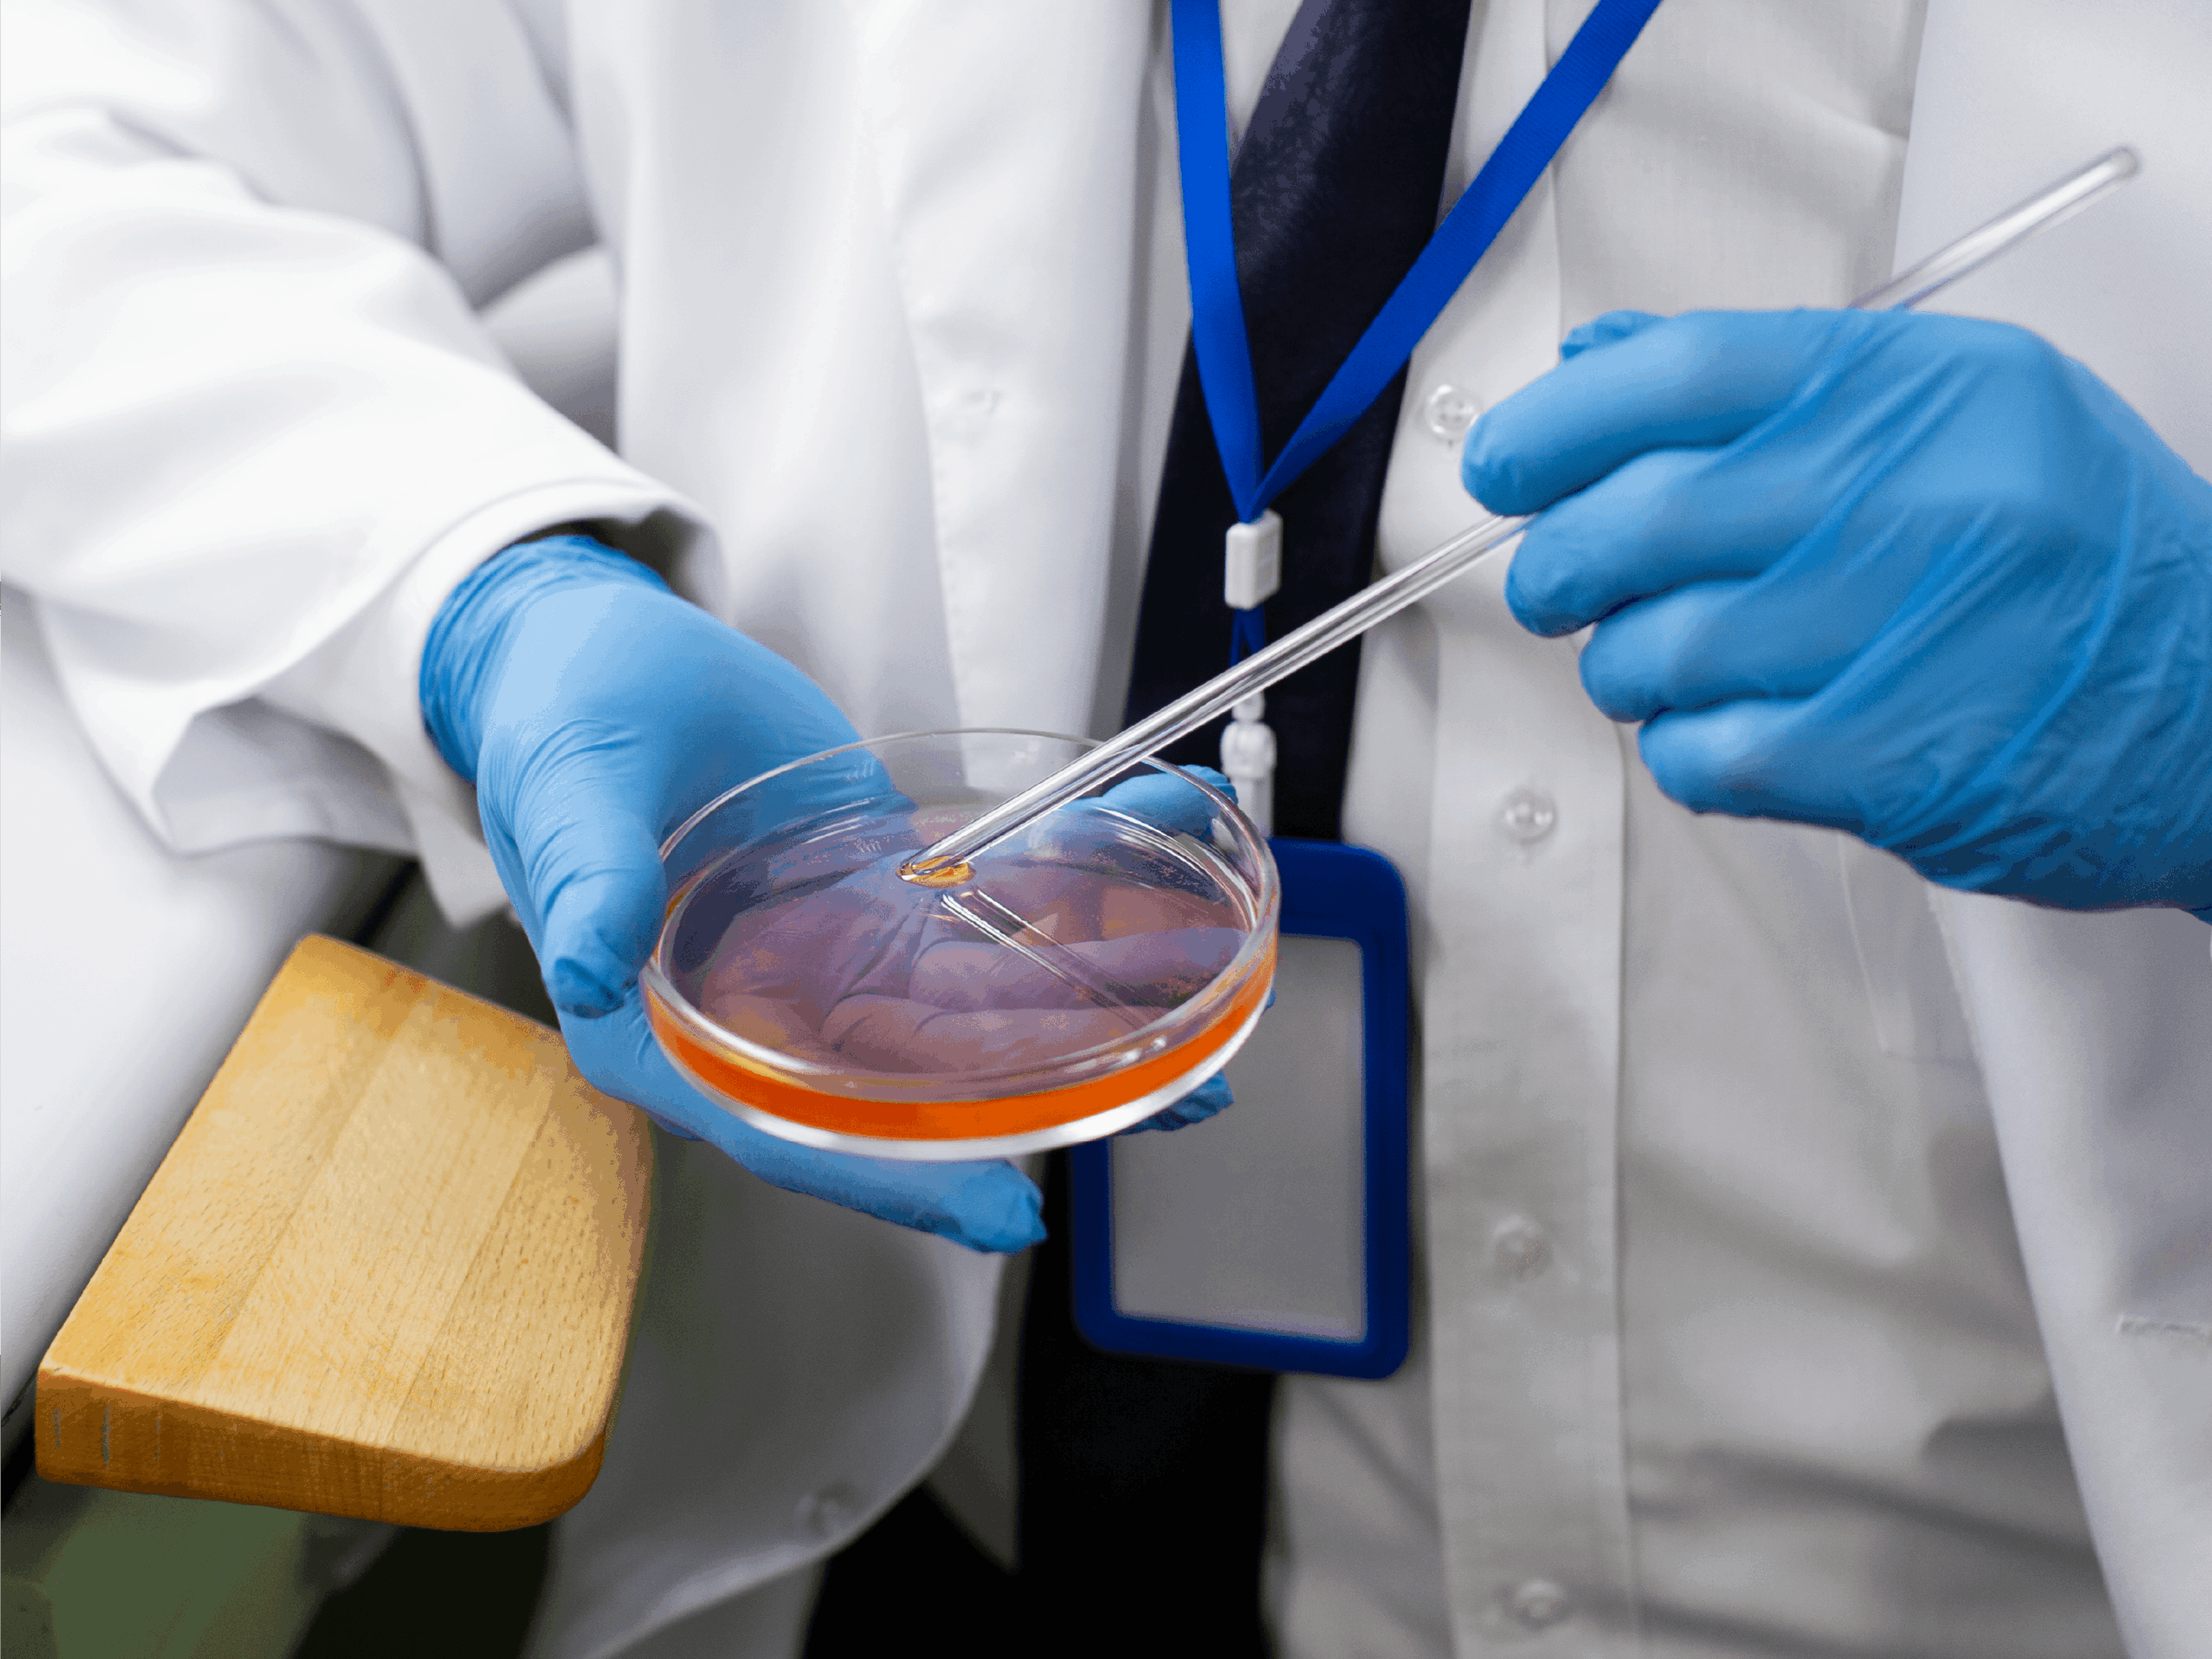

Logistic Guidelines

Genetic tests
PrenatalSafe®, GeneSafe®, BabyNext®
– Blood Sample: Blood sample or buccal swab, depending on the test.
– Storage instructions: Keep samples at room temperature unless otherwise specified.
– Special notes: Ensure that all forms, including consent forms, are completed prior to shipping.
Endometrial Receptivity Test
E-Ready™
– Sample type: Endometrial biopsy.
– Storage instructions: Store the sample in a tube with refrigeration (4-8°C)
for a minimum of 4 hours before packaging for shipping.
– Collection timing: Biopsy should be taken during the optimalwindow as directed by your clinician.


Carrier Screening
GeneScreen™
– Sample type: Blood sample (EDTA tube) or buccal swab.
– Storage instructions: Room temperature, with prompt shipping recommended to maintain sample integrity.
Genetic tests
PrenatalSafe®, GeneSafe®, BabyNext®

– Blood Sample: Blood sample or buccal swab, depending on the test.
– Storage instructions: Keep samples at room temperature unless otherwise specified.
– Special notes: Ensure that all forms, including consent forms, are completed prior to shipping.
Endometrial Receptivity Test
E-Ready™
– Sample type: Endometrial biopsy.
– Storage instructions: Store the sample in a tube with refrigeration (4-8°C)
for a minimum of 4 hours before packaging for shipping.
– Collection timing: Biopsy should be taken during the optimalwindow as directed by your clinician.
Carrier Screening
GeneScreen™

– Sample type: Blood sample (EDTA tube) or buccal swab.
– Storage instructions: Room temperature, with prompt shipping recommended to maintain sample integrity.
Assistance & Support
If you have any questions about sample collection or shipping, our customer support team is here to help.

0000-0000

